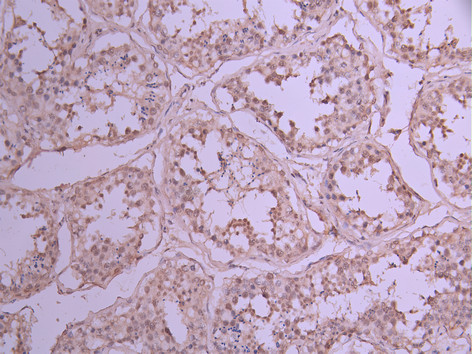

DDX20 Recombinant Monoclonal Antibody
-
中文名稱:DDX20 Recombinant Monoclonal Antibody
-
貨號:CSB-RA209536A0HU
-
規格:¥1320
-
圖片:
-
IHC image of CSB-RA209536A0HU diluted at 1:100 and staining in paraffin-embedded human colorectal cancer performed on a Leica BondTM system. After dewaxing and hydration, antigen retrieval was mediated by high pressure in a citrate buffer (pH 6.0). Section was blocked with 10% normal goat serum 30min at RT. Then primary antibody (1% BSA) was incubated at 4°C overnight. The primary is detected by a Goat anti-rabbit polymer IgG labeled by HRP and visualized using 0.05% DAB.
-
IHC image of CSB-RA209536A0HU diluted at 1:100 and staining in paraffin-embedded human testis tissue performed on a Leica BondTM system. After dewaxing and hydration, antigen retrieval was mediated by high pressure in a citrate buffer (pH 6.0). Section was blocked with 10% normal goat serum 30min at RT. Then primary antibody (1% BSA) was incubated at 4°C overnight. The primary is detected by a Goat anti-rabbit polymer IgG labeled by HRP and visualized using 0.05% DAB.
-
Immunofluorescence staining of Hela cell with CSB-RA209536A0HU at 1:50, counter-stained with DAPI. The cells were fixed in 4% formaldehyde, permeabilized using 0.2% Triton X-100 and blocked in 10% normal Goat Serum. The cells were then incubated with the antibody overnight at 4°C. The secondary antibody was Alexa Fluor 488-congugated AffiniPure Goat Anti-Rabbit IgG(H+L).
-
Overlay Peak curve showing Hela cells stained with CSB-RA209536A0HU (red line) at 1:100. The cells were fixed in 4% formaldehyde and permeated by 0.2% TritonX-100 for 10min. Then 10% normal goat serum to block non-specific protein-protein interactions followed by the antibody (1ug/1*106cells) for 45min at 4℃. The secondary antibody used was FITC-conjugated goat anti-rabbit IgG (H+L) at 1/200 dilution for 35min at 4℃.Control antibody (green line) was Rabbit IgG (1ug/1*106cells) used under the same conditions. Acquisition of >10,000 events was performed.
-
-
其他:
產品詳情
-
Uniprot No.:
-
基因名:DDX20
-
別名:Probable ATP-dependent RNA helicase DDX20 (EC 3.6.4.13) (Component of gems 3) (DEAD box protein 20) (DEAD box protein DP 103) (Gemin-3), DDX20, DP103 GEMIN3
-
反應種屬:Human
-
免疫原:A synthesized peptide from human DDX20 protein
-
免疫原種屬:Homo sapiens (Human)
-
標記方式:Non-conjugated
-
克隆類型:Monoclonal
-
抗體亞型:Rabbit IgG
-
純化方式:Affinity-chromatography
-
克隆號:17C8
-
濃度:It differs from different batches. Please contact us to confirm it.
-
保存緩沖液:Preservative: 0.03% Proclin 300
Constituents: 50% Glycerol, 0.01M PBS, PH 7.4 -
產品提供形式:Liquid
-
應用范圍:ELISA, IHC, IF, FC
-
推薦稀釋比:
Application Recommended Dilution IHC 1:50-1:200 IF 1:50-1:200 FC 1:50-1:200 -
Protocols:
-
儲存條件:Upon receipt, store at -20°C or -80°C. Avoid repeated freeze.
-
貨期:Basically, we can dispatch the products out in 1-3 working days after receiving your orders. Delivery time maybe differs from different purchasing way or location, please kindly consult your local distributors for specific delivery time.
-
用途:For Research Use Only. Not for use in diagnostic or therapeutic procedures.
相關產品
靶點詳情
-
功能:The SMN complex catalyzes the assembly of small nuclear ribonucleoproteins (snRNPs), the building blocks of the spliceosome, and thereby plays an important role in the splicing of cellular pre-mRNAs. Most spliceosomal snRNPs contain a common set of Sm proteins SNRPB, SNRPD1, SNRPD2, SNRPD3, SNRPE, SNRPF and SNRPG that assemble in a heptameric protein ring on the Sm site of the small nuclear RNA to form the core snRNP (Sm core). In the cytosol, the Sm proteins SNRPD1, SNRPD2, SNRPE, SNRPF and SNRPG are trapped in an inactive 6S pICln-Sm complex by the chaperone CLNS1A that controls the assembly of the core snRNP. To assemble core snRNPs, the SMN complex accepts the trapped 5Sm proteins from CLNS1A forming an intermediate. Binding of snRNA inside 5Sm triggers eviction of the SMN complex, thereby allowing binding of SNRPD3 and SNRPB to complete assembly of the core snRNP. May also play a role in the metabolism of small nucleolar ribonucleoprotein (snoRNPs).
-
基因功能參考文獻:
- The findings show that DDX20 may promote the progression of prostate cancer through the NF-kappaB pathway. PMID: 27121695
- In stage-adjusted analysis, the nominal associations of DDX20-rs197412, PTGS2-rs5275, and HSPA5-rs391957 with DFS were detected. However, after FDR correction none of these polymorphisms remained significantly associated with the survival outcomes PMID: 26064972
- DP103 defines metastatic potential of human breast cancers. PMID: 25083991
- Impairment of miRNA-140 function due to a deficiency of DDX20, a miRNA machinery component, could lead to hepatocarcinogenesis PMID: 22898998
- Gemin3 binds with p53, forming a complex, and plays an anti-apoptotic role by repressing the p53 expression in Saos-2 cells. PMID: 22335944
- While DDX20 normally suppresses NF-kappaB activity by regulating NF-kappaB-suppressing miRNA-140 function, this suppressive effect was lost in DDX20-deficient cells. PMID: 22445758
- we report that EBNA3C directly interacts with Gemin3 through its C-terminal domains PMID: 22174681
- NANOS1-PUMILIO2 complex, together with GEMIN3 and small noncoding RNAs, possibly regulate mRNA translation within the chromatoid body of the human germ cells. PMID: 21800163
- Data show that the two motor neuropathy-associated mutant HspB8 forms have abnormally increased binding to Ddx20. PMID: 20157854
- utilised a targeted screen to identify mRNA associated with SMN, Gemin2 and Gemin3 in the cytoplasm of a human neuroblastoma cell line, SHSY5Y PMID: 20620147
- Gemin3 and Gemin4 function in Sm core assembly and correlate the activity of this pathway with Spinal Muscular Atrophy. PMID: 16301532
顯示更多
收起更多
-
亞細胞定位:Cytoplasm. Nucleus, gem.
-
蛋白家族:DEAD box helicase family, DDX20 subfamily
-
組織特異性:Ubiquitous.
-
數據庫鏈接:
Most popular with customers
-
-
Phospho-YAP1 (S127) Recombinant Monoclonal Antibody
Applications: ELISA, WB, IHC
Species Reactivity: Human
-
-
-
-
-
-